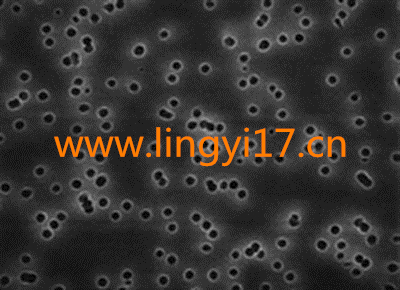
美國Millipore密理博Isopore™表面濾膜

美國Millipore密理博Isopore?表面濾膜
美國Millipore密理博Isopore?表面濾膜 | 時間: October-5 14:18:45 | 分類:其它儀器
凌儀生物提供高速離心機,美國Bio-rad伯樂電泳,德國eppendorf艾本德移液器,美國ABI基因擴增儀PCR,雅培原位雜交儀,Thermo熱電離心機等實驗室儀器設(shè)備,以及Corning康寧,Axygen愛思進(jìn),Greiner格瑞拉等耗材要省錢,別錯過哦。
產(chǎn)品介紹:
Isopore 表面濾膜是在聚碳酸酯表面徑跡蝕刻而成,推薦用于所有需要在濾膜表面觀察樣品的分析。 Isopore 表面濾膜具有獨特的適用性,通過光學(xué)或電子顯微鏡技術(shù)對空氣中的污染物及其它顆粒進(jìn)行觀察分析。 Isopore 表面濾膜由聚碳酸酯膜組成,具有光滑的,像玻璃一樣的表面,可以進(jìn)行清晰的樣品觀察。 該表面濾膜獨有的生產(chǎn)工藝保證了精確均一的孔徑,可進(jìn)行精確的依據(jù)孔徑的分離。 Isopore 表面濾膜不會污染,具有很低的背景干擾。 在絕大多數(shù)透射顯微鏡應(yīng)用中無需進(jìn)行清洗。 因為焦油和灰份重量低且穩(wěn)定,所以通常不需要重量配對濾膜。 Isopore 表面濾膜是不吸濕的,可以很快干燥,縮短樣品分析時間。
Isopore 表面濾膜是在聚碳酸酯表面徑跡蝕刻而成,推薦用于所有需要在濾膜表面觀察樣品的分析。 Isopore 表面濾膜具有獨特的適用性,通過光學(xué)或電子顯微鏡技術(shù)對空氣中的污染物及其它顆粒進(jìn)行觀察分析。 Isopore 表面濾膜由聚碳酸酯膜組成,具有光滑的,像玻璃一樣的表面,可以進(jìn)行清晰的樣品觀察。 該表面濾膜獨有的生產(chǎn)工藝保證了精確均一的孔徑,可進(jìn)行精確的依據(jù)孔徑的分離。 Isopore 表面濾膜不會污染,具有很低的背景干擾。 在絕大多數(shù)透射顯微鏡應(yīng)用中無需進(jìn)行清洗。 因為焦油和灰份重量低且穩(wěn)定,所以通常不需要重量配對濾膜。 Isopore 表面濾膜是不吸濕的,可以很快干燥,縮短樣品分析時間。
美國Millipore密理博Isopore™表面濾膜
技術(shù)指標(biāo):
顏色:白色或黑色
表面:光面
可濕性:親水
厚度:7–22 µm
成孔率:5–20%
滅菌方法:高溫高壓滅菌 (121 °C,1 bar)、EO 或 γ 射線滅菌
胰島素吸收率:3 µg/cm2
重量溶出物:< 1.0%
*Black color may fade if autoclaved.
顏色:白色或黑色
表面:光面
可濕性:親水
厚度:7–22 µm
成孔率:5–20%
滅菌方法:高溫高壓滅菌 (121 °C,1 bar)、EO 或 γ 射線滅菌
胰島素吸收率:3 µg/cm2
重量溶出物:< 1.0%
*Black color may fade if autoclaved.
| 詳細(xì)說明 | ||||||
| 應(yīng)用 | 過濾膜代碼* | 顏色 | 孔徑 (µm) | 泡點 (bar) | 水的流速 (mL/min/cm2) | 空氣流速 (L/min/cm2) |
| 趨藥性分析,生物分析,細(xì)胞學(xué),空氣監(jiān)測 | VMTP | 白色 | 0.05 | 7.1 | – | 0.35 |
| VCTP | 白色 | 0.1 | 7.1 | 0.5 | 1.5 | |
| 趨藥性分析,生物分析,細(xì)胞學(xué),空氣監(jiān)測,SEM 分析,無菌試驗 | GTTP | 白色 | 0.2 | 3.5 | 6 | 1 |
| 落射熒光顯微術(shù),顆粒監(jiān)測,空氣監(jiān)測 | GTBP | 黑色 | 0.2 | 3 | 16 | – |
| 可吸收的有機鹵化物 (AOX) 分析,空氣監(jiān)測,顆粒監(jiān)測 | HTTP | 白色 | 0.4 | 2 | 18 | 10 |
| 落射熒光顯微術(shù),顆粒監(jiān)測,空氣監(jiān)測 | HTBP | 黑色 | 0.4 | 2 | 30 | – |
| 反射光顯微技術(shù),SEM 分析,重量分析,空氣監(jiān)測 | DTTP | 白色 | 0.6 | 1.5 | 25 | 10 |
| 反射光顯微術(shù),SEM 分析,重量分析,空氣監(jiān)測,石棉監(jiān)測 | ATTP | 白色 | 0.8 | 1.2 | 40 | 20 |
| 趨藥性分析,生物分析,細(xì)胞學(xué),空氣監(jiān)測 | RTTP | 白色 | 1.2 | 1 | 110 | 20 |
| TTTP | 白色 | 2 | 0.28 | 350 | 22 | |
| TSTP | 白色 | 3 | 0.05 | 1500 | 50 | |
| 寄生蟲學(xué),趨藥性分析,生物分析,細(xì)胞學(xué),空氣監(jiān)測 | TMTP | 白色 | 5 | – | 2000 | 50 |
| 趨藥性分析,生物分析,細(xì)胞學(xué),空氣監(jiān)測 | TETP | 白色 | 8 | – | 250 | 60 |
| TCTP | 白色 | 10 | – | 250 | 69 | |
| TKTP | 白色 | 12 | – | 250 | 127 | |
| *對應(yīng)目錄編號的前 4 位 | ||||||
訂購信息:
白色過濾膜
| 目錄編號 | 濾膜孔徑,µm | 濾膜直徑,mm | 數(shù)量/包裝 |
| VMTP01300 | 0.05 | 13 | 100 |
| VCTP04700 | 0.1 | 47 | 100 |
| VCTP01300 | 0.1 | 13 | 100 |
| GTTP03700 | 0.22 | 37 | 100 |
| GTTP04700 | 0.22 | 47 | 100 |
| HTTP03700 | 0.4 | 37 | 100 |
| HTTP04700 | 0.4 | 47 | 100 |
| DTTP01300 | 0.6 | 13 | 100 |
| DTTP14250 | 0.6 | 142 | 50 |
| ATTP14250 | 0.8 | 142 | 50 |
| ATTP02500 | 0.8 | 25 | 100 |
| RTTP04700 | 1.2 | 47 | 100 |
| RTTP14250 | 1.2 | 142 | 50 |
| TTTP02500 | 2.0 | 25 | 100 |
| TTTP04700 | 2.0 | 47 | 100 |
| TSTP14250 | 3.0 | 142 | 50 |
| TSTP01300 | 3.0 | 13 | 100 |
| TMTP01300 | 5.0 | 13 | 100 |
| TMTP02500 | 5.0 | 25 | 100 |
| TMTP04700 | 5.0 | 47 | 100 |
| TETP04700 | 8.0 | 47 | 100 |
| TETP09030 | 8.0 | 90 | 30 |
| TETP14250 | 8.0 | 142 | 50 |
| TCTP04700 | 10 | 47 | 100 |
| TCTP14250 | 10 | 142 | 50 |
| TKTP01300 | 12 | 13 | 100 |
| TKTP02500 | 12 | 25 | 100 |
| TKTP04700 | 12 | 47 | 100 |
黑色過濾膜
| 目錄編號 | 濾膜孔徑,µm | 濾膜直徑,mm | 數(shù)量/包裝 |
| GTBP01300 | 0.22 | 13 | 100 |
| GTBP02500 | 0.22 | 25 | 100 |
| GTBP04700 | 0.22 | 47 | 100 |
| HTBP01300 | 0.4 | 13 | 100 |
| HTBP02500 | 0.4 | 25 | 100 |
| HTBP04700 | 0.4 | 47 | 100 |





